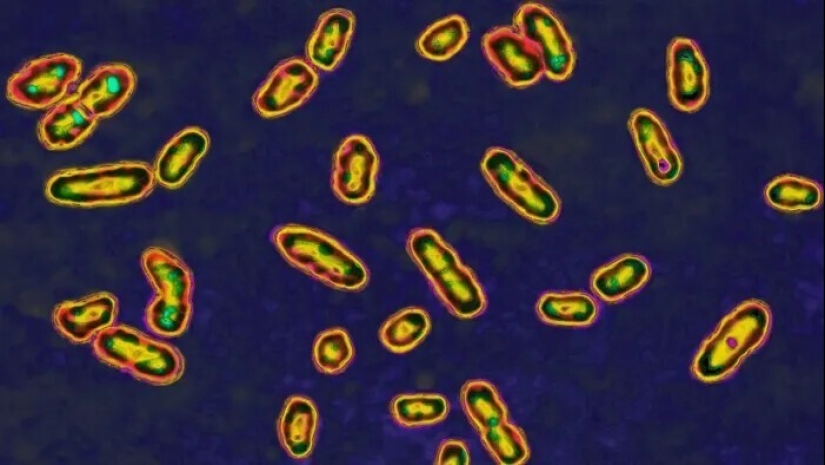
El más famoso de la epidemia en la historia de la humanidad: ¿cómo funciona? El más famoso de la epidemia en la historia de la humanidad: ¿cómo funciona?

El más famoso de la epidemia en la historia de la humanidad: ¿cómo funciona?
Categorias: Historia | Mundo | Salud y Medicina
Por Pictolic https://www.pictolic.com/es/article/el-ms-famoso-de-la-epidemia-en-la-historia-de-la-humanidad-cmo-funciona.htmlLa historia nos enseña que incluso la peor epidemia que nunca termina. Y esto, con las comodidades de hoy en día no puede sino alegrarse. Pero exactamente cómo es el final de la epidemia? Qué? Y, lo que es más importante, ¿por qué? Vamos a examinar la experiencia histórica.

Tres de los más terribles pandemias en la historia humana fue causada por la misma bacteria, el Bacilo de la plaga de la Yersinia pestis.
El primero de ellos — y la primera pandemia en la historia humana, estalló en Constantinopla, la capital del Imperio Bizantino en el año 541 BC fue traído de Egipto a través del Mediterráneo, con el homenaje que conquistó Egipto pagado el grano del Emperador Bizantino Justiniano. Con el grano a Constantinopla llegó y ratas que la propagación de las pulgas infectadas alrededor de la ciudad.
Remolino de la plaga se extendió por toda Europa, Asia y Norte de África, matando a entre 30 y 50 millones de personas — casi la mitad de la población del mundo civilizado.
La epidemia terminó, sólo cuando infectar hizo más cierta: todos los que murieron, se había enfermado de una forma o de otra, habiendo recibido la inmunidad.
La peste volvió a Europa de 800 años más tarde. La epidemia de "peste negra", que estalló en 1347, el año en que tomó cerca de 200 millones de vidas.

Fue entonces, en el siglo xiv, los Europeos por primera vez entendió claramente que la causa de la infección es conseguir el contacto con los infectados, y comenzó a tomar medidas graduales para evitar este tipo de contactos.
En primer lugar, las autoridades del puerto de Ragusa, bajo el control de Venecia: empezaron a salir de los recién llegados en barcos anclados primera en 30 años, y luego de cuarenta días. Todo este tiempo nadie tenía derecho a ir del barco a la costa. Si sólo por un período determinado, nadie a bordo, cayó enfermo, el barco podría entrar en el puerto, y los hombres, para ir a la ciudad.
Para ser una buena experiencia: infección en la ciudad se detuvo. A partir de la italiana nombres de los números 40 — "Tarantino" — y se fue de la palabra "cuarentena", que rápidamente se extendió, junto con la correspondiente práctica a través de Europa.
Londres no fue dado un respiro después de la "muerte negra". Durante 300 años, desde 1348 hasta 1665 godv capital Británica se registró cerca de 40 brotes de peste, más de una vez por década. En cada una de las epidemias en la capital Británica perecieron alrededor del 20% de la población.

Al principio del siglo XVI en gran Bretaña, primero fue la ley sobre el aislamiento de los casos. El hogar de los pacientes reportaron una bala de heno y atado a un poste o el poste frente. El que en la familia se enferma, tuvo que salir con el palo pintado de blanco. Los gatos y los perros fueron asesinados EN masa, ya que se considera que son los portadores de la peste.
Londres es una gran plaga de 1665 fue la última y más grave brote, se cobró 100.000 vidas de los Londinenses en 7 meses. Para Borba de la enfermedad de todos los eventos públicos en la ciudad han sido cancelados. Los casos de fuerza se ha abordado en sus casas, señalando la puerta de las cruces rojas y las palabras: "Dios, ten misericordia de nosotros!" Los muertos fueron arrojados en un carro y fueron enterrados en común de las zanjas. Estas medidas violentas, sin embargo, había puesto fin a la plaga para siempre.
La viruela era un nativo de "habitante" del Viejo mundo, matando a tres de cada diez casos y dejando el camino de la memoria feas cicatrices. Pero el número de muertes en Europa parecía insignificante comparado con el Nuevo mundo.

Cuando la viruela llegó a América con los primeros viajeros en el siglo xv y comenzó a cortar decenas de millones de nativos Americanos, que no tenían inmunidad natural a la enfermedad.
Sólo a finales del siglo xviii con la viruela ha sido eliminado. La salvación se convirtió en la primera en la historia de la humanidad de la vacuna. El médico británico Edward Jenner obnaruzhil que lecheras inmunes a la viruela. Como resultó, casi todos ellos fueron pereboleli cow pox, no son peligrosos para los seres humanos, y luego se vuelven inmunes a la "versión humana" de la enfermedad.
Jenner realizó un experimento: él enseñó a los 9 años de edad, hijo de su jardinero, la viruela de la vaca, y luego se le somete a las bacterias de la viruela. El niño no se enferme. Luego Jenner comenzó EN masa a aplicar este método.
Dos siglos más tarde, en 1980, la organización mundial de la salud declaró que la viruela completamente borrados de la faz de la Tierra.
En el temprano a mediados del siglo xix, el cólera ha matado en gran Bretaña, decenas de miles de personas anualmente. La medicina de esa época, afirmó que la enfermedad se propaga a través del "miasma" que figura en el mal aire.

Pero el médico Británico John Sonu sospecha de que una enfermedad grave, a matar a la gente por un par de días después de los primeros síntomas, no se esconde en el aire y en el agua potable en Londres. Estudió los registros de los hospitales y morgues, estudiando el lugar de los brotes. Él creó un mapa de muertes por cólera durante los 10 días y se encontró Custer, donde murió cerca de 500 personas, de todo el bien en la calle broad, es muy popular en la ciudad, la fuente de agua potable.
Él convenció al gobierno de la ciudad para cerrar la columna de la Ford street y la infección se detuvo. Este logro no es destruido cólera al instante — pero fue el primer paso para la comprensión de sus causas y la lucha contra la enfermedad de higiene y purificación del agua potable. Hoy en día, el cólera es destruido en los países desarrollados, pero en los países del tercer mundo sus brotes se producen periódicamente, y están asociados con la calidad del agua potable.
Palabras clave: Https://www.history.com/news/pandemics-end-plague-cholera-black-death-smallpox
Publicar artículo de noticiasArtículos Recientes
¡Qué actores no tienen que soportar para conseguir e interpretar el codiciado papel! Incluso en la era de la tecnología moderna, ...
Prohibición comenzó en 1920, cuando el llamado de la Volstead act, entró en vigor. La 18ª enmienda a la Constitución de los ...

Hoy en día, se puede ver cada vez más a personas hurgando en los botes de basura, eligiendo qué pueden comer o utilizar de ...